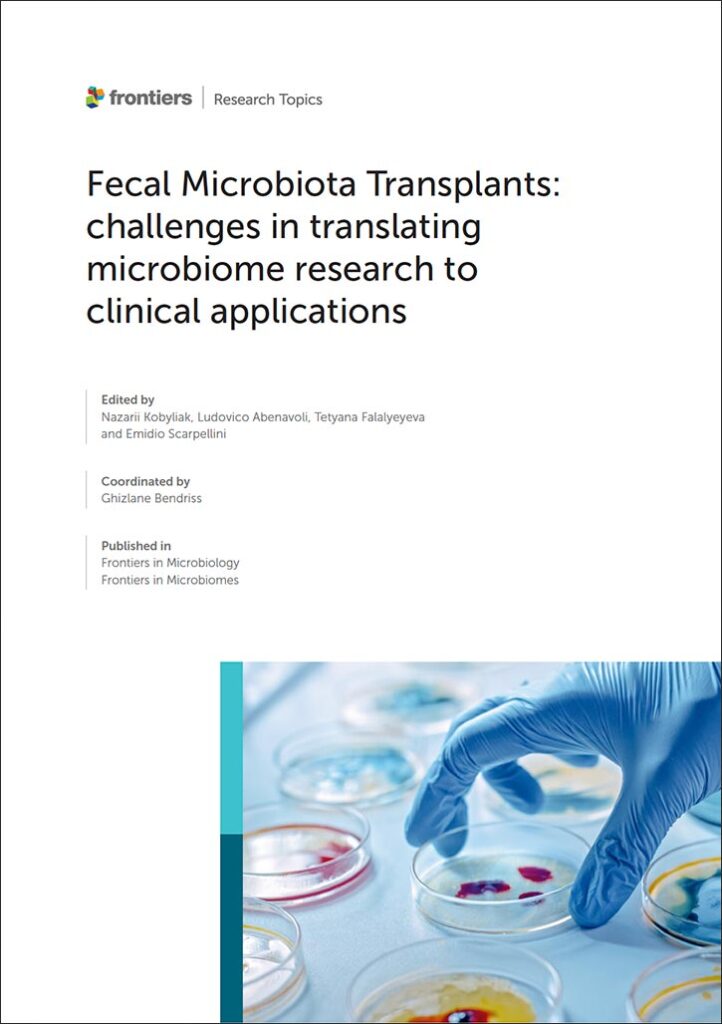
WCM-Q-coordinated e-book on fecal microbiota transplants surpasses 100,000 views WCM-Q-coordinated e-book on fecal microbiota transplants surpasses 100,000 views - wcm-q-coordinated e-book

Doha – January 12, 2026: An e-book coordinated by a WCM-Q researcher which compiles the latest research into the use of fecal transplants to restore healthy gut microbiota has proven so successful it is to be relaunched in an expanded form next year.
The e-book, titled, ‘Fecal Microbiota Transplants: challenges in translating microbiome research to clinical applications,’ has garnered more than 100,000 views in only one month since its publication in Frontiers in Microbiology, one of the most cited open access microbiology research journals. Following that success, the journal has invited the editorial team to launch a second volume of the e-book to capitalize on the upswell of interest in the topic.
The first volume of the e-book, of which WCM-Q assistant professor of biology Dr. Ghizlane Bendriss is the research topic coordinator, featured 26 research articles examining the challenges preventing fecal microbiota transplants (FMT) from becoming adopted into mainstream clinical practice. The procedure, which involves transplanting a healthy stool sample from a donor into the gastrointestinal tube of a patient with an unbalanced gut microbiome showing a loss of diversity, has been found to be effective at re-establishing a diverse gut flora in the recipient, but widespread adoption remains elusive.
While the procedure is most commonly used to treat recurrent Clostridium difficile infections, research has also demonstrated the potential efficacy of fecal transplantation for a wide range of illnesses, including gastrointestinal conditions like irritable bowel syndrome, ulcerative colitis, Crohn’s disease; metabolic conditions like type 2 diabetes, obesity, metabolic syndrome and insulin resistance; and even neurological conditions like Parkinson’s disease, Alzheimer’s disease, autism, and multiple sclerosis. There is also research into the efficacy of fecal transplants for treating autoimmune conditions such as rheumatoid arthritis and lupus; mental health conditions like anxiety disorders, depression, bipolar disorders, and schizophrenia; as well as improving response to cancer treatments.
Dr. Bendriss, who holds a Ph.D. in neuroscience, said: “Fecal microbiota transplants show promise as treatments for a wide variety of conditions, yet progress in translation into clinical applications has been slow. This e-book is a collection of accepted manuscripts highlighting the challenges that are preventing the widespread clinical adoption of FMT, which include difficulty in finding and screening healthy donors, regulatory challenges, technical difficulties relating to collection, storage and transport of stool samples, difficulty predicting outcomes, and the lack of known biomarkers to assess the success of transplants, among many others.”
However, Dr. Bendriss said that new developments in the field of multi-omics, now increasingly coupled with artificial intelligence to enable large-scale pattern detection and in-depth study of metabolic processes, provide new tools for testing the effectiveness of fecal transplants. WCM-Q is a regional pioneer in the study of multi-omics, including metabolomics, metagenomics and proteomics, and has also developed advanced capabilities in AI and machine learning research in recent years.
“Since we published the first volume of the e-book, multi-omics techniques have advanced a great deal and this is really exciting for fecal microbiota researchers because it gives us tools for understanding with far greater clarity how a transplant has affected a patient or a particular disease state,” she added. “Launching a second research topic call will allow us to invite new studies exploring how metabolomics and AI-driven analysis of multi-omics data can help overcome current challenges, and hopefully, ultimately, support the translation of microbiome research into evidence-based FMT clinical interventions that improve patient outcomes.”